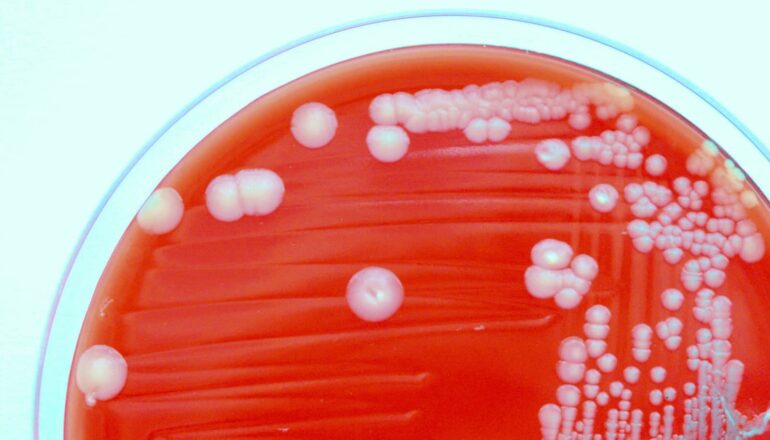

How some antibiotics keep working against resistant bacteria
- Researchers have made a breakthrough in understanding how some antibiotics can still work against resistant bacteria.
- The study used advanced imaging technology and computer simulations to visualize how aminoglycoside antibiotics attach to ribosomes, which are modified by bacteria to block these drugs.
- Some aminoglycosides, such as amikacin and arbekacin, have chemical features that allow them to “pivot” or bend within their binding spot, making them less susceptible to resistance.
- The study identified a common modification that completely prevents any aminoglycoside from attaching, explaining why some bacteria are untreatable with this class of drugs.
- The findings provide valuable insights for designing new antibiotics that can overcome bacterial defenses and stay ahead of the growing threat of antibiotic resistance.
Researchers have made a major step forward in understanding how some antibiotics manage to keep working even against resistant bacteria.
Antibiotic resistance is one of the most urgent health challenges of our time. As more bacteria evolve ways to fight off medicines, infections that were once easily treated are becoming harder—and sometimes impossible—to cure.
The new findings in Nature Communications could help researchers design new, more effective drugs to fight dangerous infections.
Many antibiotics work by targeting the ribosome—the machine inside cells that makes proteins. Some bacteria protect themselves by adding small chemical “tags” to the ribosome. These tags block some antibiotics from binding, stopping them from working effectively. This form of resistance has been showing up more often in major disease-causing bacteria such as E. coli, Klebsiella pneumoniae, and Salmonella.
When this happens with a class of drugs called aminoglycosides (which include commonly used antibiotics like gentamicin and amikacin), even a single chemical tag can make all the drugs in this class useless—a problem known as “pan-resistance.”
The researchers used advanced imaging technology, known as cryo-electron microscopy, to capture the first-ever high-resolution pictures of how aminoglycoside antibiotics attach to resistant ribosomes. They also used powerful computer simulations to watch, in fine detail, how these drugs move and shift at the atomic level.
Their results showed that while most aminoglycosides are blocked by ribosome modifications, some can “pivot” or bend within their binding spot. This small adjustment allows them to get around the chemical roadblock and continue working. For example, drugs like amikacin and arbekacin have chemical features that give them this flexibility.
However, the study also revealed that not all chemical modifications can be avoided. One common modification completely prevents any aminoglycoside from attaching, explaining why some bacteria are untreatable with this class of drugs.
“By combining lab experiments with large-scale computer modeling, we aim to establish a blueprint for what makes an antibiotic more likely to succeed against this form of resistance in bacteria,” says Debayan Dey, assistant professor of biochemistry in Emory University’s School of Medicine and co-first author of the paper.
“Our work sets out design rules that can guide the development of new antibiotics—ones better able to overcome bacterial defenses.”
As drug resistance continues to spread, these kinds of insights are critical for staying one step ahead in the fight against superbugs.
Source: Emory University
The post How some antibiotics keep working against resistant bacteria appeared first on Futurity.
